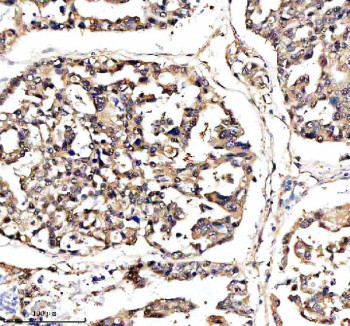
Anti-DNAJB6 / DnaJ homolog subfamily B member 6

Cookie preferences
This website uses cookies, which are necessary for the technical operation of the website and are always set. Other cookies, which increase the comfort when using this website, are used for direct advertising or to facilitate interaction with other websites and social networks, are only set with your consent.
Configuration
Technically required
These cookies are necessary for the basic functions of the shop.
"Allow all cookies" cookie
"Decline all cookies" cookie
CSRF token
Cookie preferences
Currency change
Customer-specific caching
FACT-Finder tracking
Individual prices
Selected shop
Session
Comfort functions
These cookies are used to make the shopping experience even more appealing, for example for the recognition of the visitor.
Note
Show the facebook fanpage in the right blod sidebar
Statistics & Tracking
Affiliate program
Conversion and usertracking via Google Tag Manager
Track device being used
| Item number | Size | Datasheet | Manual | SDS | Delivery time | Quantity | Price |
|---|---|---|---|---|---|---|---|
| NSJ-FY12376 | 100 µg | - | - |
3 - 10 business days* |
790.00€
|
If you have any questions, please use our Contact Form.
You can also order by e-mail: info@biomol.com
Larger quantity required? Request bulk
You can also order by e-mail: info@biomol.com
Larger quantity required? Request bulk
Adding 0.2 ml of distilled water will yield a concentration of 500 ug/ml. The DNAJB6 antibody... more
Product information "Anti-DNAJB6 / DnaJ homolog subfamily B member 6"
Adding 0.2 ml of distilled water will yield a concentration of 500 ug/ml. The DNAJB6 antibody targets DnaJ homolog subfamily B member 6, a molecular chaperone encoded by the DNAJB6 gene. This protein belongs to the Hsp40 (DnaJ) family, which functions as a co-chaperone of Hsp70, facilitating protein folding, quality control, and aggregation prevention. DnaJ homolog subfamily B member 6 plays a key role in maintaining proteostasis and protecting cells from misfolded protein stress. The DNAJB6 antibody enables specific detection of this versatile chaperone, making it an essential reagent for studying protein homeostasis, neurodegeneration, and myopathies.DnaJ homolog subfamily B member 6 exists in two major isoforms produced by alternative splicing: a long nuclear/cytoplasmic form (DNAJB6a) and a shorter cytoplasmic form (DNAJB6b). Both isoforms cooperate with Hsp70 to stabilize unfolded or aggregation-prone proteins, particularly under stress conditions such as heat shock or oxidative damage. The DNAJB6 antibody detects these isoforms, allowing analysis of expression patterns and subcellular localization in response to proteotoxic stress.Mutations in DNAJB6 cause limb-girdle muscular dystrophy type D1 (LGMDD1), a progressive neuromuscular disorder characterized by protein aggregation and muscle weakness. The DNAJB6 antibody is crucial for studying the molecular basis of this disease, enabling quantification of mutant and wild-type protein levels and their aggregation propensity. DnaJ homolog subfamily B member 6 has also been shown to suppress polyglutamine aggregation in Huntington's disease models, highlighting its broader neuroprotective role. The DNAJB6 antibody supports investigations into these mechanisms by providing reliable detection in neuronal and muscle tissues.Beyond its function in proteostasis, DnaJ homolog subfamily B member 6 participates in transcriptional regulation and signal transduction. It interacts with components of the Wnt/beta-catenin pathway, influencing gene expression and cellular differentiation. The DNAJB6 antibody allows exploration of these noncanonical functions, revealing how chaperones integrate protein quality control with developmental signaling. Elevated expression of DNAJB6 has been associated with enhanced stress resistance and reduced metastasis in some cancer cells, further emphasizing its physiological relevance.The DNAJB6 antibody is validated for western blotting, immunofluorescence, and immunohistochemistry. It provides clear cytoplasmic and nuclear localization depending on isoform distribution. NSJ Bioreagents supplies this antibody as a high-specificity, reproducible reagent for proteostasis and neuromuscular disease research. By enabling comprehensive study of DnaJ homolog subfamily B member 6, the DNAJB6 antibody supports discovery in protein folding, neurodegeneration, and molecular chaperone biology.
| Keywords: | Anti-MRJ, Anti-MSJ-1, Anti-HHDJ1, Anti-DNAJB6, Anti-Heat shock protein J2, Anti-DnaJ homolog subfamily B member 6, DNAJB6 Antibody / DnaJ homolog subfamily B member 6 |
| Supplier: | NSJ Bioreagents |
| Supplier-Nr: | FY12376 |
Properties
| Application: | WB, IHC |
| Antibody Type: | Polyclonal |
| Conjugate: | No |
| Host: | Rabbit |
| Species reactivity: | human, mouse, rat |
| Immunogen: | A synthetic peptide corresponding to a sequence at the C-terminus of human DNAJB6 |
| Format: | Purified |
Database Information
| KEGG ID : | K09512 | Matching products |
| UniProt ID : | O75190 | Matching products |
| Gene ID : | GeneID 10049 | Matching products |
Handling & Safety
| Storage: | +4°C |
| Shipping: | +4°C (International: +4°C) |
Caution
Our products are for laboratory research use only: Not for administration to humans!
Our products are for laboratory research use only: Not for administration to humans!
Information about the product reference will follow.
more
You will get a certificate here
Viewed